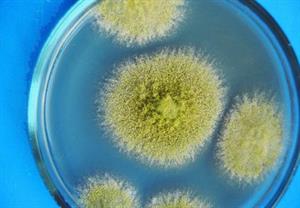
пліснява8.jpg

Встанови відповідність між зображенням та приналежністю до різних груп грибів:
1) цвілеві гриби — ;
2) шапинкові пластинчасті гриби — ;
3) гриби-паразити — ;
4) шапинкові трубчасті гриби — ;
Варіанти відповідей:

Ви повинні авторизуватися, щоб відповісти на завдання. Будь ласка, увійдіть в свій профіль на сайті або зареєструйтеся.